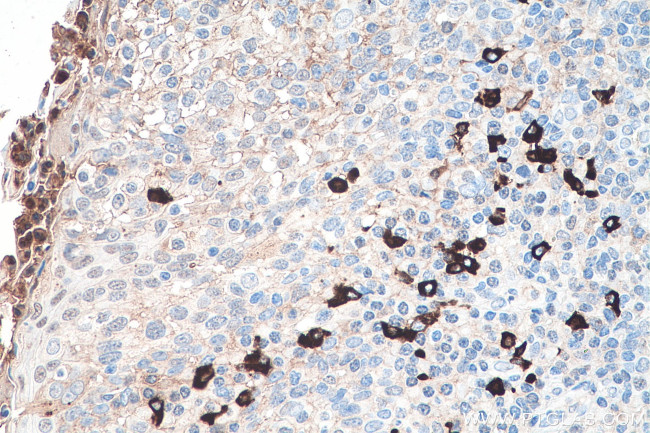
Heavy chain of IgG4 Antibody in Immunohistochemistry (Paraffin) (IHC (P))

Search
Proteintech
Heavy chain of IgG4 Monoclonal Antibody (1A1A2)
{{$productOrderCtrl.translations['antibody.pdp.commerceCard.promotion.promotions']}}
{{$productOrderCtrl.translations['antibody.pdp.commerceCard.promotion.viewpromo']}}
{{$productOrderCtrl.translations['antibody.pdp.commerceCard.promotion.promocode']}}: {{promo.promoCode}} {{promo.promoTitle}} {{promo.promoDescription}}. {{$productOrderCtrl.translations['antibody.pdp.commerceCard.promotion.learnmore']}}
产品信息
66408-1-IG
种属反应
宿主/亚型
分类
类型
克隆号
抗原
偶联物
形式
浓度
规格
纯化类型
保存液
内含物
保存条件
运输条件
产品详细信息
This antibody detects the heavy chain of human IgG4. The immunogen of this antibody is the specific domain "NKGLPSSIEK" of IGHG4.
靶标信息
The regions of relatively constant sequence beyond the variable regions of immunoglobulins are termed constant regions (C regions) and are present in both the heavy and light chains. With very few exceptions, the sites of attachment for carbohydrates on immunoglobulins are located in these C regions. These regions also function to hold the variable regions together by using the disulfide bond between them. The C regions facilitate interaction with the antigen by increasing the maximum rotation of the immunoglobulin arms. Several studies have shown that a large population of patients with recurrent respiratory tract infection have low IgG4 concentrations.
仅用于科研。不用于诊断过程。未经明确授权不得转售。
生物信息学
蛋白别名: Immunoglobulin G; ImmunoglobulinG; ImmunoglobulinG4
Entrez Gene ID: (Human) 3503